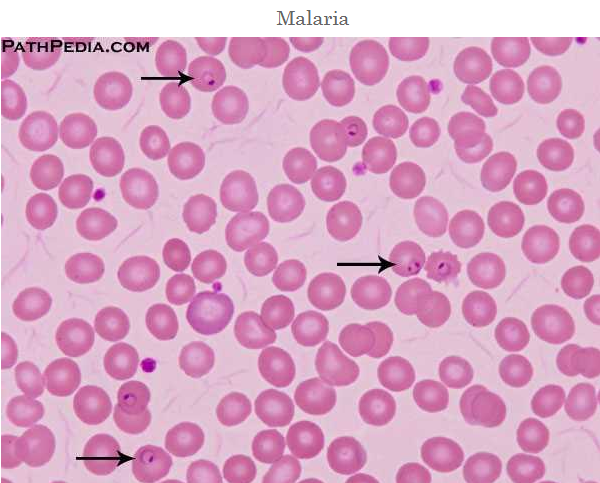

Материал: Zadanie_Zachet_1
Задание № 1
Заполнить перфокарту, правильные ответы выделить желтым или зеленым цветом. Внизу таблицы указать цикл развития.
Простейшие
Тип ____простейшие(protozoa)______________ Фамилия__Белолугова__________
Класс__Жгутиковые(flagellata)____________________ Группа ___СТ-20-03________ ____
Представитель_Трипаносома африканская (Trypanosoma gambiense)
( Trypanosoma brucei gambiense, Trypanosoma brucei rhodesiense) _ Правильные ответы выделить желтым или зеленым цветом
Название заболевания __ африканский трипаносомоз (сонная болезнь) ___
Места обитания и локализация |
Образ жизни |
Внешнее строение |
Внутреннее строение |
Размножение и переносчики |
Диагностика |
Практическое значение |
Внешняя среда Позвоночные животные Беспозвоночные животные Человек Клетка Плазма крови Лейкоциты Эритроциты Кишечник: Толстый тонкий Урогенитальная система Печень Спинномозговая жидкость Мышцы Кожа Слизистые оболочки: Рта носа Костный мозг Центральная нервная система Сердце |
Одиночные Колониальные Прикрепленные Подвижные Автотрофы Гетеротрофы Миксотрофы Осмотическое питание Сапрофиты Паразиты Свободноживущие Образуют цисты Цисты не образуют |
Реснички Жгутики Псевдоподии Ундулирующая мембрана Блефаропласт Кутикула Пелликула Цитолемма Присасывательный диск Цитостом Цитофаринкс Форма тела постоянная Форма тела непостоянная
|
Ядро одно Ядра два Пищеварительная вакуоль Сократительная вакуоль Цитоплазма Аксостиль Хроматофоры Стигма Базальное тельце Трихоцисты
Строение цисты: одноядерная двухъядерная четырехъядерная восьмиядерная округлая овальная |
Бесполое Половое Чередование поколений есть Чередования поколений нет Конъюгация Шизогония Продольное деление Поперечное деление Спорогония Гаметогония
Переносчики: комар москит муха це-це триатомовый клоп комнатная муха клещ блоха вошь мошка слепень мокрец таракан
|
По нахождению цист По нахождению вегетативных форм
При исследовании: плазмы крови эритроцитов лейкоцитов фекалий мочи дуоденального сока спинномозговой жидкости клеток костного мозга клеток печени мазков урегинальной системы содержимого язв кожи пунктатов лимфатических узлов мышц
|
Патогенные организмы Непатогенные организмы Бессимптомные паразиты Возбудители болезней человека Возбудители болезней животных Ядовитые организмы Показатели загрязненности воды Возбудители : природно-очаговых болезней трансмиссивных заболеваний инфекционных заболеваний венерических заболеваний |
Запишите цикл развития: Trypanosoma brucei gambiense: Трипаносомные формы => муха це-це (при кровососании больного человека), в желудке мухи они размножаются => переходят в хоботок. Здесь трипаносомные формы => критидиальные, они размножаются => переходят в метациклические. Муха кусает здорового человека => передает ему метациклические формы. В организме человека метациклические формы => трипаносомные. Они размножаются в крови и лимфе, затем => в лимфатические узлы, с/м жидкость, ткани спинного и головного мозга. ИНВАЗИОННАЯ ФОРМА – метациклическая. Trypanosoma brucei rhodesiense: Цикл в организме мухи тот же самый. Отличие в том, что муха заражается не от человека, а от диких животных, которые и служат основным резервуаром. Заражение человека происходит главным образом при укусах мух во время поездок по необжитой местности, на охоте
Трипаносома африканская.
2 - Определить паразитических простейших, написать латинские названия и строение, указать цикл развития паразита (рис.1).
Рис.1
Plasmodium falciparum – тропическая малярия.
Имеет 3 основных формы - трофозоиты (эндозоиты), цисты и ооцисты.
1) Трофозоиты имеют форму полумесяца. На переднем конце - специальные органеллы для проникновения в клетку - коноид, роптрии, микронемы. Пелликула (из 3-х мембран) + фибриллы => наружный скелет. Питание микропорами на поверхности тела. Скопление трофозоитов внутри одной клетки называют псевдоцистой
2) Цисты формируются в организме хозяина, имеют собственную плотную оболочку. Внутри содержится 3000-5000 паразитов и более. Через плотную оболочку цист не проникают ни антитела, ни лекарственные препараты. Они очень устойчивы к различным воздействиям и в организме хозяина сохраняются десятки лет. Большая часть их локализуется в скелетных мышцах, миокарде, центральной нервной системе.
3) Ооцисты представляют собой образования овальной формы диаметром 10-12 мкм. Они формируются в слизистой оболочке тонкой кишки некоторых представителей семейства кошачьих и выделяются с испражнениями. Ооцисты при благоприятных условиях сохраняются во внешней среде до 1 года и более. Именно они играют основную роль в передаче инфекции.
Промежуточный хозяин - птицы, млекопитающие, человек. Окончательный хозяин - семейство кошачьих. Характерно бесполое размножение путем продольного деления и эндогонии (внутреннее почкование). Ооцисты с токсоплазмами => кишечник промежуточного хозяина => эпителиальные клетки, здесь они размножаются => накопление трофозоидов в эпителиальных клетках => образуют севдоцисты, а при хроническом токсоплазмозе и настоящие цисты => кишечник основного хозяина. Здесь происходит половое размножение => микро- и макрогаметоциты, они сливаются => зигота => ооциста => человек.
3 – Ответить на вопросы теста
Выбрать правильный ответ.
1. К трансмиссивным природно-очаговым заболеваниям относятся
а) амёбиаз
б) лямблиоз
в) кожный лейшманиоз
г) балантидиаз
2. Размножение малярийного плазмодия
а) коньюгация, продольное деление, шизогония
б) продольное деление, амитоз, гаметогония
в) шизогония, спорогония, гаметогония
г) спорогония, коньюгация, анизогамия.
3. Место локализации балантидий в организме человека
а) кровь
б) аппендикс
в) тонкая кишка
г) толстая кишка.
4. Промежуточний хозяин в жизненном цикле малярийного плазмодия
а) комар
б) москит
в) человек
г) жвачные животные.
5. Окончательный хозяин токсоплазмозы
а) человек
б) кошка
в) грызуны
г) птицы.
6. Диагноз на амёбиаз
а) по обнаружению 4-х ядерных цист или вегетативной формы в фекалиях
б) по обнаружению 8-ми ядерных цист в фекалиях
в) по обнаружению вегетативных форм в дуоденальном содержимом
г) по обнаружению цист в дуоденальном содержимом.
7. Компоненты природного очага кожного лейшманиоза
а) грызуны, москиты
б) собаки, волки
в) москиты, свиньи
г) свиньи, комары.
8. Компоненты природного очага американского трипаносомоза
а) обезьяны, собаки
б) москит, мухи
в) триатомовый клоп, обезьяны, броненосцы, грызуны
г) человек, трипаносомозы.
9. Переносчики амёбиаза и балантидиаза являются
а) комары
б) москиты
в) мухи
г) блохи
10 Диагноз на малярию - исследование
а) лимфы
б) клеток костного мозга
в) крови до приступа
г) крови во время приступа.